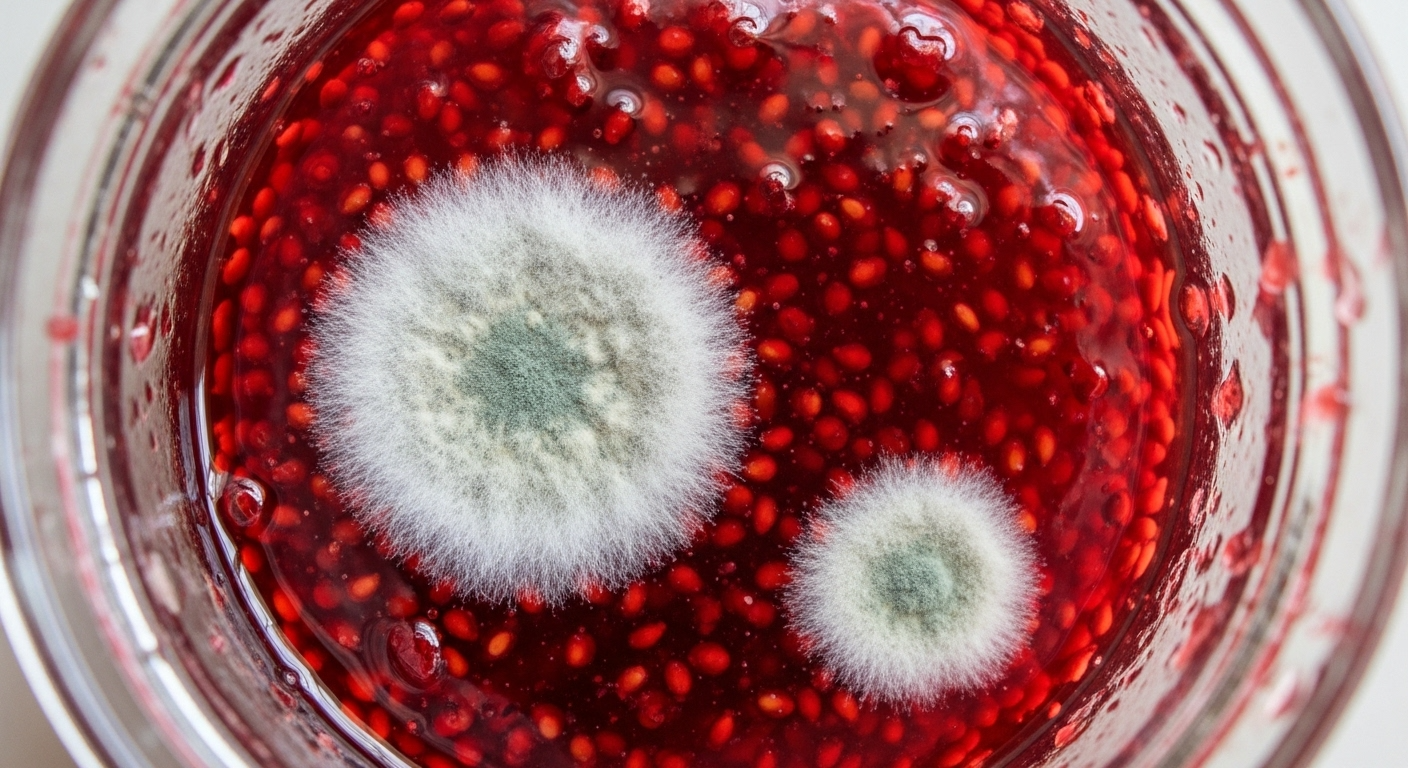
Еда с «сюрпризом»: что будет, если съесть продукт с плесенью

Что такое плесень?
Плесень – это микроскопический нитевидный грибок, размножающийся спорами. На еду она может попасть различными способами – через воздух, воду и контакт с зараженными продуктами.
Некоторые виды плесени вырабатывают сильные аллергены, поэтому опасны для людей. Также плесень на продукте указывает на то, что он испортился – помимо плесневых грибков еда заражена и бактериями, которые способны вызвать серьезные пищевые отравления. Еще одна угроза – микотоксины. Это ядовитые вещества, выделяемые некоторыми видами плесени. На сегодня выявлены более 300 микотоксинов. Самый известный из них – канцероген афлатоксин, способный поражать печень и почки человека.
Плесень легко размножается, достаточно создать ей благоприятные условия:
- Высокая влажность. Плесень очень любит тепло и влагу. Хлеб, фрукты и овощи наиболее подвержены заражению.
- Поврежденная тара. Треснутая или порванная упаковка могут стать «воротами» для спор на продуктах.
- Грязная посуда. Остатки пищи на посуде и разделочных досках – прекрасная среда для развития грибков.
- Неправильное хранение. Чтобы избежать появления плесени, продукты следует хранить в условиях, указанных на упаковке.
- Плохая обработка продуктов. Росту грибков может способствовать плохо вымытые овощи и фрукты или недостаточно термически обработанное мясо.
Виды плесени: опасные и безопасные
Серая плесень – довольно прожорливый и неприхотливый грибок. Он способен быстро разрастаться и глубоко проникать в продукты. Серая плесень опасна для человеческого организма.
Зеленая плесень любит влажную среду. Она распространяется гораздо быстрее своих собратьев. Зеленую плесень часто можно встретить в молочных продуктах, выпечке, овощах и фруктах. Здоровый человеческий организм сможет с легкостью переварить плесень. Если же иммунитет ослаблен, то употребление плесени в пищу грозит проблемами. В любом случае, лучше не рисковать и выбросить продукты, пораженные зеленой плесенью.
Розовая плесень. Это вид относится к малоопасным. Розовая плесень размножается на гниющих продуктах и пищевых отходах. Еду, зараженную такой плесенью, употреблять не рекомендуется.
Белая плесень. Выглядит как пушок, чаще всего поражает хлеб и сыр, также ее можно встретить в горшках комнатных растений. Есть продукты, пораженные белой плесенью, не стоит – при ослабленном иммунитете она может навредить пищеварительной системе.
Голубая плесень – безопасный вид. Она активно используется в сыроварении. Продукты с этой плесенью можно употреблять в пищу.
Черная плесень – самая распространенная и опасная. Чаще всего ее целью являются фрукты, овощи и хлеб. Что будет, если съесть черную плесень? Ее грибки могут стать причиной пищевого отравления и вызвать серьезную аллергическую реакцию. Поэтому, если в продуктах поселилась черная плесень, их необходимо сразу выбросить.
Что будет если съесть еду с плесенью?

К сожалению, плесень – нередкий гость на наших кухнях. Наверное, у каждого бывало, когда при осмотре еда выглядела свежей, а при ее поедании ощущается неприятный вкус. Самые частые продукты, в которых прячутся грибки – хлеб, сыр, лаваш, клубника, пирожные, булочки. Плесень порой появляется и там, где ее не ждешь, например, в открытом вчера пакетированном соке и распознать ее получается не сразу. Что же будет, если случайно съесть плесень?
Результат употребления продуктов с плесенью может зависеть от ее типа, количества съеденного и индивидуальной реакции организма. В большинстве случаев это не вызовет серьезных последствий, особенно если у человека нет проблем с иммунитетом.
Если же организм ослаблен, то «плесневелая трапеза» рискует обернуться пищевым отравлением с тошнотой и рвотой. К перечисленным признакам отравления плесенью может добавиться метеоризм и диарея.
В еде с плесенью могут активизироваться возбудители сальмонеллеза – опасного заболевания со множеством побочных эффектов. Пораженные плесенью мясо, молоко и домашние консервы могут содержать токсин, провоцирующий острое токсико-инфекционное заболевание – ботулизм.
Нередко последствия употребления продуктов с плесенью не ограничиваются проблемами с пищеварением. У некоторых людей могут возникнуть аллергические реакции. Проявляются они в виде высыпаний на коже, зуда, заложенности носа и покраснения глаз.
Вероятны и менее специфические симптомы – повышение температуры тела, ухудшение зрения, общая слабость, боли в суставах. Также могут наблюдаться нарушения сна, раздражительность и спутанность сознания.
От употребленной в пищу плесени страдает и дыхательная система. Появление одышки, приступов удушья, частые бронхиты или пневмонии – все это последствия деятельности грибков.
Некоторые люди не понимают, почему нельзя есть продукты с плесенью, мол плесень периодически появляется в еде и никаких страшных последствий они не ощущали, но употребление еды с грибками может носить отложенный характер. При продолжительном воздействии плесени на организм могут появиться проблемы с печенью и почками, а также развиться аутоиммунное заболевание, при котором организм атакует свои же клетки.
Как поступить, если случайно съел продукты с плесенью?
Довольно часто бывает так, что съел кусок хлеба с плесенью, не сразу смог распознать несвежий торт или полакомился ягодой «с сюрпризом». Что делать если случайно съел еду с плесенью? Как мы уже сказали, в большинстве случаев ничего плохого произойти не должно. Но об этом факте следует помнить примерно в течение 24-х часов, так как нередко реакция организма на плесень бывает отсрочена. При симптомах отравления и аллергических реакциях следует обратиться к врачу и рассказать ему, что вероятной причиной плохого самочувствия стала плесень.
Можно ли спасти продукты с плесенью?
Если на продукте немного плесени, то появляется соблазн срезать ее, а остальное просто съесть, но так можно делать далеко не со всякой едой. Дело в том, что налет, который мы видим на хлебе, ягоде, пирожном или колбасе, – это только вершина айсберга. Невидимые нити грибка ушли глубоко внутрь продуктов, туда же попали споры и бактерии, распространяющиеся по ходу роста грибковых нитей. Именно поэтому еда, даже немного пораженная плесенью, должна быть без сожаления выброшена. Сохранить можно только продукты с плотной структурой – в неё грибковые нити не могут проникнуть быстро.
Продукты, которые безоговорочно следует выбросить:
- мягкие овощи и фрукты – огурцы, помидоры, персики, сливы;
- консервированные и квашеные продукты;
- хлеб, булки, лаваш, торт и пирожные;
- молочные продукты, кроме твердого сыра.
Обязательной утилизации подлежит любая готовая еда – будь то суп, запеченное мясо или макароны. Без сожаления выбрасывайте орехи и пасту на их основе.
Некоторые хозяйки переваривают заплесневевшие овощи, варенья или консервы, но делать так нельзя – термическая обработка способна уничтожить бактерии и споры грибка, но против микотоксинов она бессильна.
У многих не стоит вопрос – что делать, если съел заплесневелый хлеб. Якобы умудренные опытом граждане режут батон на кусочки и отправляют в духовку, делая из хлеба сухари. Они думают, что высокая температура убивает плесень, но они ошибаются. Поэтому для собственного же здоровья следует отправить испортившийся хлеб в мусорку.
Есть продукты, которые можно сохранить. К ним относится твердый сыр. Чтобы плесневелый продукт сделать безопасным, нужно вокруг пораженного участка обрезать не менее чем по 2,5 см. Таким же образом можно спасти и твердые овощи – картофель, капусту и морковь. Сыровяленые колбасы, пораженные грибками, тоже можно употреблять в пищу. Плесень на их поверхности – норма. Однако, прежде чем употребить в пищу колбасу, необходимо удалить налет жесткой щеткой.
Если вы заметили, что пища покрылась плесенью, ни в коем случае не нюхайте ее – вдыхание спор может привести к аллергическим реакциям. Испорченные продукты следует положить в пакет, хорошо завязать и выбросить мусорный бак. Место, где лежала пораженная плесенью еда, нужно тщательно вымыть. Также необходимо проверить близлежащие продукты – в них могли попасть споры грибка.
Как предотвратить рост плесени на кухне?
Чтобы рост плесени свести к минимуму, следует помнить простые правила:
- Нарезанные фрукты и овощи, мясо и рыбу, приготовленную еду сразу после приема пищи надо закрывать крышкой или затягивать пленкой и убирать в холодильник.
- Консервы из металлических банок следует перекладывать контейнеры или стеклянные банки, плотно закрывать и хранить в холодильнике.
- Готовую пищу нельзя хранить в холодильнике дольше четырех суток.
- Споры плесени накапливаются в кухонных губках, поэтому менять их следует хотя бы раз в неделю.
- Каждые несколько месяцев проводите в холодильнике ревизию и тщательно мойте в нем внутренние поверхности.
Что будет если съесть сыр с плесенью?

Плесневые грибки широко применяются в сыроделии. Из некоторых видов делают любимые многими рокфор, дорблю, камамбер и бри. Сырная плесень может быть белой, голубой, зеленой. Пользы у нее нет, но и вреда организму она не приносит. Однако людям со слабым иммунитетом, беременным и маленьким детям рекомендуют воздерживаться от употребления сыров с плесенью.
Сами по себе они безопасны, но часто изготавливаются из непастеризованного молока. Например, при транспортировке в сыр могут попасть опасные виды грибков, которые нанесут вред здоровью.
Если вы считаете, что вам уже доводилось есть продукты с плесенью и негативных реакций не произошло – совсем не означает, что это безопасно. Да, последствия наступают не всегда, но разновидностей плесени много, и знать заранее, как повлияет определенный токсин на организм, невозможно. Поэтому без сожаления выбрасывайте продукты даже с небольшой плесенью – рисковать здоровьем не стоит.
Читайте также:
Полив кабачков в открытом грунте: как часто, какой водой и другие вопросы
Чугунная скатерть–самобранка: как правильно обжечь новый чугунный казан на огне
Пустоцвет на огурцах в теплице и открытом грунте: что делать
Правила землепользования и застройки земельного участка: что это такое и зачем нужны









